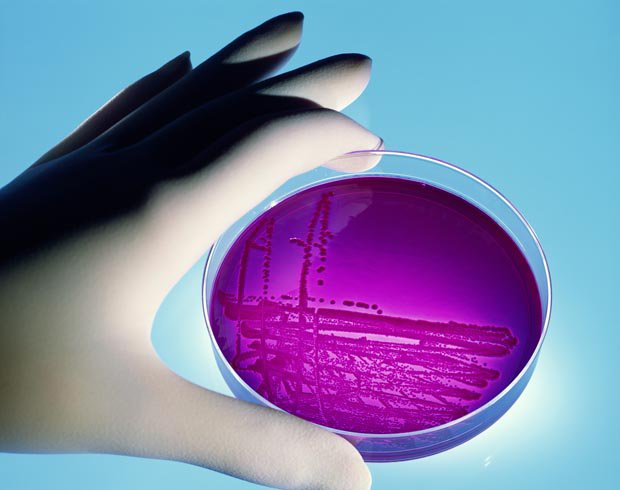

KFC has launched an investigation after the chain was caught serving ice with bacteria from faeces on it.
 THE COLONEL: Would you like poo with that?
THE COLONEL: Would you like poo with that?
The discovery was made at the KFC branch in Birmingham's Martineau Place by researchers from BBC One's Rip Off Britain show.
They were looking into food hygiene standards at several big name takeaways and coffee shops.
Experts warned customers could get sick from the bug – faecal coliform.
KFC said it was “extremely disappointed” and has launched a probe.
 DANGEROUS: Faecal coliform bacteria on a petri dish
DANGEROUS: Faecal coliform bacteria on a petri dish
Dr Margarita Gomez Escalada, who examined the results at Leeds Beckett University, told the programme: "We found high levels of bacteria in the ice.
“The presence of faecal coliform suggests that there's faecal contamination either on the water that made the ice, or the ice itself, and so it increases the risk of getting sick from consuming this ice."
In a statement KFC told the programme that it was "extremely disappointed" by the ice test results adding that it had "immediately launched an investigation".
KFC also said they were undertaking "a retraining programme with all team members on our standards for touch point cleaning and procedures".
The restaurant chain added that it takes "food safety and hygiene extremely seriously".

No comments:
Post a Comment